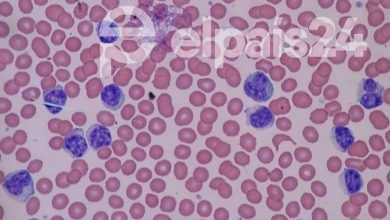

Periodistas de Hong Kong son reprimidos de igual manera que los manifestantes
No es la primera vez que hablamos sobre las propuestas de Hong Kong, tampoco será la última vez que lo haremos. Las influencias occidentales y orientales están teniendo un choque titánico debido a las diferentes ideologías políticas. Pero hoy no nos concentraremos en eso, sino en un grupo de terceros. Los Periodistas de Hong Kong y la violencia que estos sufren.
Cortesía de South China Morning Post
El maltrato que reciben los periodistas de Hong Kong es directamente proporcional al de los protestantes.
Una de las principales quejas que presenta el gremio internacional de periodistas es el hecho que ellos sufren de represión. Con represión nos referimos a la misma resistencia violenta que sufren los manifestantes de Hong Kong. Se podría decir que un periodista está tan sujeto a salir herido como si estuviera apoyando a estas activamente.
Parte de las formas de represión que sufren los periodistas de Hong Kong consta del mismo tipo de resistencia que se usa contra los manifestantes. Esto incluye golpes y aporreos por las fuerzas policiales, incluso llegando aconstar de aerosol pimienta. En última instancia, los periodistas podrían enfrentarse a heridas de balas de goma.
Hasta ahora se reporta una cantidad bastante alta de actos de represión y violencia contra los periodistas. Tenemos que tan solo en el último mes de Agosto y sus protestas correspondientes, se reportaron 30 casos. Si lo vemos a gran escala no parece tanto, pero al contar que esto sucedió en sólo un mes, deja a entender que se reprimió a un periodista diariamente.
Cortesía de The Online Citizen
Un Periodista en específico salió a la luz a hablar sobre la represión cuando se le dio de alta en el hospital
Un caso especial es el de Holmes Chan, uno de los periodistas de Hong Kong que se enfocó en transmitir el evento de una protesta de manera en vivo. Cuando las autoridades se dieron cuenta que Holmes podía poner a los medios en su contra, lo silenciaron. Holmes fue golpeado y luego rociado con gas pimienta.
El caso de Holmes se atendió de manera urgente en un hospital pues el estar rociado no le permitió seguir trabajando. No fue sino hasta horas después que Holmes se recuperó prontamente, pero el aérosol le causó una quemadura química ocular. Es aquí donde gracias a Holmes se crea una investigación sobre los casos de los periodistas.
Otros periodistas se han unido a este movimiento para contrarrestar la represión contra sus camaradas. Los periodistas de Hong Kong explican que las relaciones con las autoridades se han deteriorado en los últimos meses. Esto es especialmente verídico cuando los reporteros desean indagar sobre casos que implican arrestos indebidos a manifestantes.